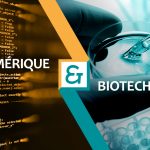
Atlanpole_format 1200x724-numerique-et-sante

A NE PAS MANQUER CE MOIS-CI : APPELS A PROJETS, AGENDA, INTERNATIONAL…
A NE PAS MANQUER CE MOIS-CI : APPELS A PROJETS, AGENDA, INTERNATIONAL...
|
SAVE THE DATE
|
|
|
Open Innovation Camp > TRANSITION[S]
Le 04/07/2019 | TITAN - la Maison HEBEL - Ile de Nantes 44000
Le rendez-vous annuel de l'innovation numérique collaborative du Grand Ouest
OPEN INNOVATION CAMP 2019
TRANSITION[S]
Comment le numérique accompagne
les...
|
|
|
|
|
|
APPELS A PROJETS
|
|
|
ANR FLASH Sécurité des jeux olympiques et paralympiques de paris 2024 2019
Date de cloture : 22/05/2019
Appel à projets « flash » Sécurité des jeux olympiques et paralympiques de paris 2024
Les Jeux olympiques et paralympiques de Paris se tiendront...
|
|
|
|
|
ANR LABCOM Laboratoires communs organismes de recherche publics – PME / ETI (LabCom) 2019
Date de cloture : 11/10/2019
Laboratoires communs organismes de recherche publics - PME / ETI (LabCom)
L’objet de ce programme est d’inciter les acteurs de la recherche académique...
|
|
|
|
|
ANR FLASH Pratiques de recherche et données ouvertes 2019
Date de cloture : 27/05/2019
L’appel Flash, prévu dans le cadre du plan national pour la science ouverte, représente une opportunité d’accélérer la maturation des diverses...
|
|
|
|
|
|
OBJECTIF EUROPE & INTERNATIONAL
|
Saisissez les opportunités pour accélérer votre développement à l'étranger...
|
Appels à projets
|
|
|
Solutions innovantes pour la ville durable en Afrique
Date de cloture : 14/06/2019
La direction générale du Trésor a lancé, le 14 mars, un appel à projets doté d'une enveloppe de 5 millions d'euros pour financer des innovations...
|
|
|
|
|
COMMISSION EUROPEENNE COPERNICUS MASTERS 2019
Date de cloture : 30/06/2019
Contexte : la neuvième édition des Copernicus Masters offre la possibilité aux participants de développer des solutions afin de répondre à des...
|
|
|
|
|
COMMISSION EUROPEENNE H2020 EUROPE Security for smart and safe cities 2019
Date de cloture : 22/08/2019
Specific Challenge:
In the cities, public spaces such as malls, open crowded gathering areas and events, and non-restricted areas of transport infrastructures,...
|
|
|
|
|
COMMISSION EUROPEENNE H2020 EUROPE Divers AAP Cyber sécurité 2019
Date de cloture : 19/11/2019
APPELS A PROJETS EUROPEENS SUR LA CYBER SECURITE:
• SU-INFRA02-2019: Security for smart and safe cities, including for public spaces: https://ec.europa.eu/research/participants/portal/desktop/en/opportunities/h2020/topics/su-infra02-2019.html
Deadline...
|
|
|
|
|
COMMISSION EUROPEENNE Open Call The Next Generation Internet (NGI) initiative 2019
Date de cloture : 31/12/2019
The Next Generation Internet (NGI) initiative has launched four new Open Calls. The calls provide funding opportunities for cutting-edge Research and Innovation...
|
|
|
|
|
Appels à projets Européens par thème
Date de cloture : 31/12/2020
Chercher des appels à projets par thème:
Animal welfare, plant health, public health and food safety
Agriculture and rural development
Bank and...
|
|
|
|
Evènements
|
|
|
EUREKA GLOBAL INNOVATION SUMMIT
Du 14/05/2019 au 16/05/2019 | Manchester
Le Sommet mondial de l’innovation d’EUREKA est un lieu de rencontre international où les entreprises et les agences d’innovation peuvent réseauter,...
|
|
|
|
|
GEO Business 2019
Du 21/05/2019 au 22/05/2019 | Londres
Technologie géospatiale : façonner l'avenir
L'événement géospatial conçu pour toutes les personnes impliquées dans la collecte, le stockage, le...
|
|
|
|
|
Business Expedition : Philippines
Du 27/05/2019 au 03/06/2019 | Manille, Philippines
La Coopérative #AngersFrenchTech propose une nouvelle Business Expedition à l’international
en partenariat avec
A l’occasion du PSECE (Philippines...
|
|
|
|
|
Minalogic Business Meetings – MBM Grenoble 2019
Le 28/05/2019 | WTC Grenoble
Images & Réseaux est partenaire des rendez-vous d'affaires internationaux des technologies du numérique
le 28 mai 2019 à Grenoble.
Convaincus...
|
|
|
|
|
|
|
|
|
|
A VOTRE AGENDA !
|
|
|
Matinée-débat « Quels intérêts à se transformer vers l’industrie de demain ? »
Le 21/05/2019 | ICAM Vendée à la Roche-sur-Yon (amphithéâtre Agora)
Cette rencontre-débat est organisée et animée par Images & Réseaux et ADN Ouest, en partenariat avec EMC2 dans le cadre du Printemps de l’innovation...
|
|
|
|
|
ESTIMnumérique
Le 23/05/2019 | Technicolor Rennes
En tant que membre du bureau d'ESTIMNumérique, Images & Réseaux est partenaire de l'Event pour promouvoir les métiers du numérique auprès des...
|
|
|
|
|
Debrief CES et VIVATECH
Le 24/05/2019 | Rouen
Le Pôle TES et le Syntec Numérique, en partenariat avec Keyveo, organisent un debriefing à destination des délégations normandes sur les 2 grands...
|
|
|
|
|
Manifestation SecNumÉco Normand
Le 28/05/2019 | Colombelles
Cette manifestation, organisée* par L’Agence Nationale de la Sécurité des Systèmes d’Information (ANSSI) et le Service de l’Information Stratégique...
|
|
|
|
|
MEET’UP GREENTECH VERTE
Le 04/06/2019 | Station F - Paris
Le Ministère de la Transition écologique et solidaire organise son Meet'Up 2019 de sa communauté de start-up Greentech verte le mardi 4 juin de...
|
|
|
|
|
Web2Day
Du 05/06/2019 au 07/06/2019 | Nantes
Humain, vibrant et intense. Le Web2day, c’est le festival des professionnels et des passionnés des nouvelles technos qui ont envie de s’inspirer,...
|
|
|
|
|
Technoférence #29 Smart Industrie : Process chic et performance choc
Le 06/06/2019 | Rennes et en visioconférence (Lannion, Quimper, Nantes, Saint-Brieuc, Vannes)
Venez découvrir la vision de la smart industrie de grands groupes, PME et laboratoires académiques du territoire ! Organisée par Images & Réseaux,...
|
|
|
|
|
IN NORMANDY 2019
Du 06/06/2019 au 07/06/2019 | Parc des Expositions, Rouen
C'est LE rendez-vous normand de l’innovation et du numérique pour les entreprises, les collectivités et les décideurs. Avec plus de 250 solutions...
|
|
|
|
|
NUMÉRIQUE & BIOTECH : une alliance incontournable
Le 18/06/2019 | IRT b<>com, Rennes
Atlanpole Biotherapies, ID2Santé, Images & Réseaux et le Pôle TES
co-organisent cette année deux événements sur l'innovation numérique dans...
|
|
|
|
|
INFO DAY “Smart & Safe – Energy & Mobility””
Le 20/06/2019 | Siège du Ministère de l'Enseignement Supérieur, de la Recherche et de l'Innovation (MESRI) - Paris
L’Alliance Smart French Energy Clusters (SFEC), en collaboration avec les Points de contact Nationaux (P.C.N.) Energie, TIC, Transports et Sécurité...
|
|
|
|
|
Atelier financement de la Recherche
Le 20/06/2019 | Caen
Le Pôle TES organise un Atelier autour des différents dispositifs de financement de la Recherche.
RENDEZ-VOUS
le 20 juin prochain à 8h30,
en...
|
|
|
|
|
CONNECT, le rendez-vous des solutions numériques
Le 25/06/2019 | MMArena – Le Mans
UNE JOURNÉE POUR ACCÉLÉRER VOS PROJETS NUMÉRIQUES
Au programme de cette 7e édition :
Des RDV d’affaires,
Des conférences d’experts,
...
|
|
|
|
|
|
RETOUR SUR LE MAG
|
|
|
Images & Réseaux + TES au centre des nouvelles stratégies industrielles
Il faudra attendre pour connaitre son nom définitif… mais déjà l'ensemble "I&R + TES" affirme son positionnement. Au sein du réseau des Digital...
|
|
|
|
|
Smart Energies : Il faut engager l’utilisateur dans la maîtrise de sa consommation
L'adaptation des usages est un des leviers de la transition énergétique : il faudra apprendre à consommer lorsque l'énergie propre est disponible....
|
|
|
|
|
Excense réinvente le dialogue professionnel par le digital
Depuis un peu plus de cinq ans, Excense creuse une même idée : s'appuyer sur le potentiel des écrans tactiles pour enrichir la rencontre entre les personnes....
|
|
|
|
|
La transition énergétique se réalise par l’engagement des territoires
Le monde de l'énergie évolue vite : le consommateur devient aussi producteur, les véhicules sont de plus en plus électriques, les priorités sont à...
|
|
|
|
|
BROAD-TATOU, l’antipiratage du streaming vidéo
Classiquement, le tatouage vidéo marque chaque copie d'un film pour permettre de remonter à la source d'un piratage. Mais comment faire dans le cas d'une...
|
|
|
|
|
Ndmac Systems : sucess story dans l’univers des brasseries
Ndmac Systems, jeune PME membre d’Images & Réseaux et conceptrice d’une machine de distribution de liquides réfrigérés a récemment été labellisée...
|
|
|
|
|
Créée par des enseignants, la startup EduMoov s’attaque à l’adaptive learning
En quelques années, la plateforme EduMoov s'est transformée de projet amateur en startup performante et structurée. Spécialisée dans les outils destinés...
|
|
|
|
|
Recensement usages futurs basés sur la 5G
La DGE a lancé un recensement auprès des entreprises innovantes des usages futurs basés sur la 5G.
L’objectif est de faire un état des lieux des...
|
|
|
|
|
Enquête sur les pratiques de veille des entreprises bretonnes
L’intelligence économique contribue pleinement à la compétitivité des entreprises via la mise en place de démarches structurées de collecte, d’analyse...
|
|
|
|
|
|
ILS VIENNENT DE NOUS REJOINDRE... BIENVENUE AU POLE !
|
|
|
PIX-FACTORY
Créations de supports de communication visuelles - Images et animations 3D / photos et vidéos / applications / expériences virtuelles / observations...
|
|
|
|
|
BLUE (BRETAGNE TELECOM)
Fondé en 2005 par Nicolas Boittin, Blue (ex-Bretagne Télécom) accompagne les directeurs des systèmes d’information des entreprises et collectivités...
|
|
|
|
|
OUEST MEDIALAB
Le cluster et labo des médias met en mouvement les acteurs de l'information et de la communication autour du numérique et accélère leurs projets d'innovation.
|
|
|
|
|
EXPANDIUM (VIAVI SOLUTIONS)
Expandium fournit aux opérateurs de réseaux mobiles, traditionnels (2G, 3G, LTE ou 5G) et rail (GSM-R and ERTMS), une vision à 360° sur leur réseau...
|
|
|
|
|
INSTITUT DE CANCEROLOGIE DE L’OUEST
Né de la fusion en janvier 2011 du Centre de Lutte Contre le Cancer « Paul Papin » d'Angers et du Centre de Lutte Contre le Cancer « René Gauducheau...
|
|
|
|
|
EASYBROADCAST
EasyBroadcast offre une solution innovante de streaming OTT bout-en-bout, de l’ingestion du contenu à sa diffusion. Une technologie brevetée qui permet...
|
|
|
|
|
|

|
Les revues de presse du pôle
|
|
On parle de nous dans la Presse !
Retrouvez ici l'ensemble des revues de presse du pôle Images & Réseaux mois par mois.
Revue de...
|
|
|
|
|
|
|
|
Venez découvrir notre forum d’échange de services vous permettant d’offrir et/ou de rechercher une solution technologique, une expérimentation, une compétence.
|
|
|
|
|
|
|
|

















![[W2D19] Affiche](https://www.images-et-reseaux.com/voy_content/uploads/2018/11/w2d19-affiche-150x150.png)